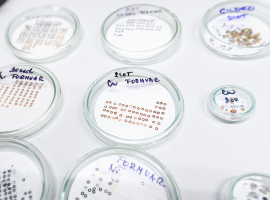
CZBI-5

Přijďte se podívat na svět mikroskopem! Posviťte si na vzorky – a vzorky budou svítit zpátky na vás.
Věda začíná otázkou. A často také dobrým mikroskopem. Podíváte se do mikroskopu na skutečné buňky a fluorescenčně značené struktury, které doslova svítí před očima. Vyzkoušíte si přípravu vzorku pro elektronový mikroskop s pomocí „vodní laboratoře“ a pak uvidíte, jak takový vzorek vypadá ve skutečnosti. Nahlédnete do embryí dánia pruhovaného a zjistíte, proč je tato malá rybka velkým pomocníkem vědy. Seznámíte se s robotickými technologiemi, které zvládnou zpracovat obrovské množství vzorků během jediného dne. Prozkoumejte svět, který je menší než zrnko prachu – ale má obrovský význam pro naše zdraví.
Czech-BioImaging je česká výzkumná infrastruktura, která propojuje špičková zobrazovací pracoviště napříč republikou. Pomáhá vědkyním a vědcům nahlížet do nitra buněk, tkání i celých organismů – a to v neuvěřitelných detailech. Díky moderním mikroskopům dokážeme sledovat děje v živých buňkách téměř v přímém přenosu. Jak se buňka dělí? Jak putují molekuly uvnitř buňky? Co se pokazí při vzniku nemoci?
CZ-OPENSCREEN se zaměřuje na objevování biologicky aktivních látek – hledáme molekuly, které by jednou mohly sloužit jako základ nových léčiv. Testujeme tisíce sloučenin a zjišťujeme, jak ovlivňují konkrétní biologické procesy. Jak najít tu správnou molekulu mezi miliony možností? A jak poznáme, že by z ní mohl být lék?
https://www.img.cas.cz/vyzkum/vyzkumne-infrastruktury/